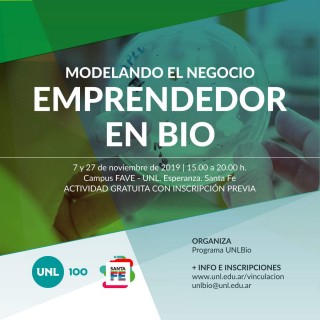

Taller: Modelando el negocio emprendedor en Bio
Martes 22 de octubre de 2019 / Actualizado el miércoles 23 de octubre de 2019
La modalidad del taller apunta al “aprender haciendo” como estrategia privilegiada para el desarrollo de los conocimientos, habilidades y actitudes en las personas que participen.
El objetivo es fortalecer y fomentar generación de ideas para la concepción de emprendimientos exitosos y la igualdad de oportunidades.
Se trabajarán 4 ejes temáticos:
1- Generación de ideas e identificación de oportunidades;
2- Reconocimiento de habilidades y saberes;
3- Herramientas Lean – Canvas para el diseño de modelos, estrategias para innovar en modelos de negocios;
4- Validación y tablero de experimentos.
+Info: https://www.unl.edu.ar/agenda/index.php?act=showEvento&id=23393
Inscripción: https://servicios.unl.edu.ar/unleventos/personas/register/taller_modelando_el_negocio_emprendedor_en_bio_1
Espere por favor....
Espere por favor....